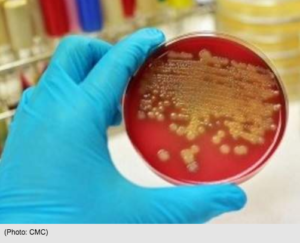

HAITIAN-TRUTH.ORG Proud to be Haiti's most informative NEWS site
The FLAME OF TRUTH is flickering near oblivion. We are dedicated to fanning them with facts. Truth will empower Haitians
LINKS
- AIMER HAITI
- ARISTIDE
- Current STORM MAP of Haiti
- EMBASSY/CONSULAR OFFICES – USA
- Haiti Action
- HAITI EN MARCHE
- HAITI OBSERVATEUR
- HAITI PROGRESS ENGLISH
- HAITI PROGRESS FRENCH
- IJDH
- LE MATIN – HAITI
- LE MATIN FRANCE
- LE MONDE
- LE NOUVELLISTE HAITI
- LOS ANGELES TIME
- MIAMI HERALD
- MINUSTAH
- NATIONAL HURRICANE CENTER
- NEW YORK TIMES
- ORGANIZATION OF AMERICAN STATES
- PREVAL
- Randy Mont-Reynaud's Haiti Blog~HAITI NEXT DOOR
- UNITED NATIONS
- WALL STREET JOURNAL
- WASHINGTON POST
Archives
- April 2026
- March 2026
- February 2026
- January 2026
- December 2025
- November 2025
- October 2025
- September 2025
- August 2025
- July 2025
- June 2025
- May 2025
- April 2025
- March 2025
- February 2025
- January 2025
- December 2024
- November 2024
- October 2024
- September 2024
- August 2024
- July 2024
- June 2024
- May 2024
- April 2024
- March 2024
- February 2024
- January 2024
- December 2023
- November 2023
- October 2023
- September 2023
- August 2023
- July 2023
- June 2023
- May 2023
- April 2023
- March 2023
- February 2023
- January 2023
- December 2022
- November 2022
- October 2022
- September 2022
- August 2022
- July 2022
- June 2022
- May 2022
- April 2022
- March 2022
- February 2022
- January 2022
- December 2021
- November 2021
- October 2021
- September 2021
- August 2021
- July 2021
- June 2021
- May 2021
- April 2021
- March 2021
- February 2021
- January 2021
- December 2020
- November 2020
- October 2020
- September 2020
- August 2020
- July 2020
- June 2020
- May 2020
- April 2020
- March 2020
- February 2020
- January 2020
- December 2019
- November 2019
- October 2019
- September 2019
- August 2019
- July 2019
- June 2019
- May 2019
- April 2019
- March 2019
- February 2019
- January 2019
- December 2018
- November 2018
- October 2018
- September 2018
- August 2018
- July 2018
- June 2018
- May 2018
- March 2018
- February 2018
- January 2018
- December 2017
- November 2017
- October 2017
- September 2017
- August 2017
- July 2017
- June 2017
- May 2017
- April 2017
- March 2017
- February 2017
- January 2017
- December 2016
- November 2016
- October 2016
- September 2016
- July 2016
- June 2016
- May 2016
- April 2016
- March 2016
- February 2016
- January 2016
- December 2015
- November 2015
- October 2015
- September 2015
- August 2015
- July 2015
- June 2015
- May 2015
- April 2015
- March 2015
- February 2015
- January 2015
- December 2014
- November 2014
- October 2014
- September 2014
- August 2014
- July 2014
- June 2014
- May 2014
- April 2014
- March 2014
- February 2014
- January 2014
- December 2013
- November 2013
- October 2013
- September 2013
- August 2013
- July 2013
- June 2013
- May 2013
- April 2013
- March 2013
- February 2013
- January 2013
- December 2012
- November 2012
- October 2012
- September 2012
- August 2012
- July 2012
- June 2012
- May 2012
- April 2012
- March 2012
- February 2012
- January 2012
- December 2011
- November 2011
- October 2011
- September 2011
- August 2011
- July 2011
- June 2011
- May 2011
- April 2011
- March 2011
- February 2011
- January 2011
- December 2010
- November 2010
- October 2010
- September 2010
- August 2010
- July 2010
- June 2010
- May 2010
- April 2010
- March 2010
- February 2010
- January 2010
- December 2009
Tags
Africa
aristide
army
arnel Belizaire
Bellerieve
border
caribbean
caricom
ceant
CEP
citizenship
cocaine
coronavirus
corruption
Covid-19
Crime
Dominican republic
Drugs
earthquake
election
elections
haiti
Haiti-election-lamothe-martelly-education-broken promise-
Haiti- elections
Haiti- Prime minister- Evans Paul- Martelly- elections- caribbean crime
haitian
haitian elections
Haiti Carnival
Haiti election
Haiti elections- elections-haitian-Moise Jean Charles- Arnel Belizaire-crime-aristide-
jude celestin
lamothe
Laurent Lamothe
lavalas
martelly
minustah
murder
Parliment
petro caribe
President
preval
Prime Minister
racism
usa
Wyclef
Copyright © 2026 HAITIAN-TRUTH.ORG Proud to be Haiti's most informative NEWS site